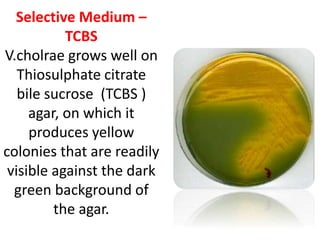
Selective Medium –
TCBS
V.cholrae grows well on
Thiosulphate citrate
bile sucrose (TCBS )
agar, on which it
produces yellow
colonies that are readily
visible against the dark
green background of
the agar.
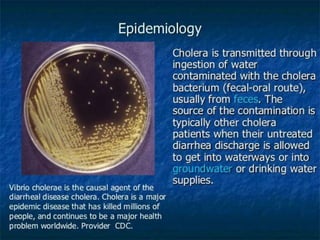

This document discusses Vibrio cholerae, the bacteria that causes cholera. It describes the morphology and characteristics of V. cholerae, including that it is a curved, motile rod shaped bacteria. It also covers the history of its discovery, methods of diagnosis from stool samples, cultural characteristics on selective media, and pathogenesis of cholera. Treatment involves oral rehydration to replace fluids and electrolytes lost from diarrhea and vomiting.